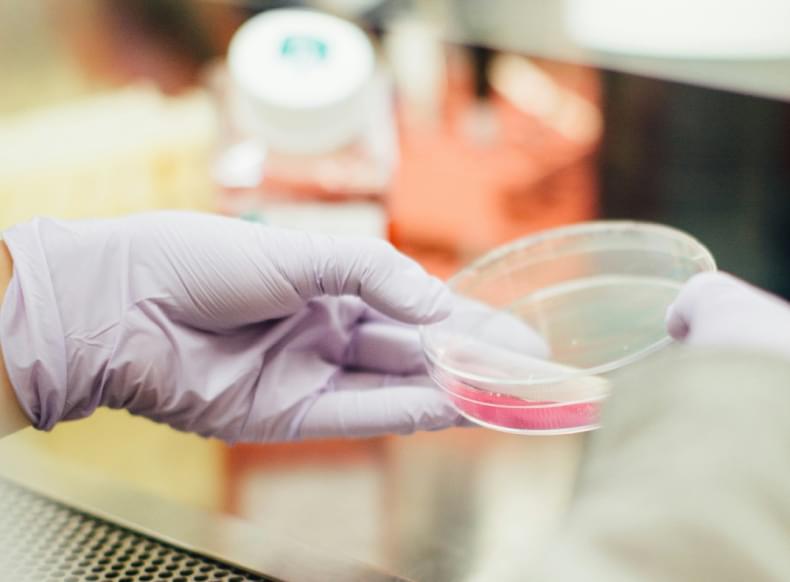

Aesti on pühendunud raba saadustest valmistatud toimivate ilutoodete loomisele, kus harmooniliselt ühinevad looduslikud koostisosad ja kaasaegne iluteadus. Terviklikud tooted peegeldavad meie põhiväärtusi – looduslikkus, jätkusuutlikkus ja kvaliteet.

Me ei tee järeleandmisi koostisosade osas – iga tooraine peab olema kõrgeima kvaliteediga ning hoolikalt valitud nii looduslike, kui ka teaduspõhiste alternatiivide hulgast. Usume tasakaalu looduse väe ja tõestatud toimete vahel, et pakkuda lahendusi, mis päriselt toimivad.

Aesti on pühendunud tervislikule ja looduslähedasele ilule
-
Puhas loodus
Meie tooted pärinevad rabast, looduslikult puhtast kohast. Hoolitseme keskkonna eest, minimaliseerides pakendeid ja kasutades tootmisjääke. Plastiku vältimiseks otsime paremaid lahendusi ja julgustame kliente pakendeid õigesti sorteerima.
-
Parima kvaliteediga ja puhas tooraine
Usume, et ilu ei vaja keemiat. Valime hoolikalt toorained, uurides nende päritolu ja käitlemist. Välistame kõik kahtlase või ebaselge päritoluga toorained, tagades, et meie tooted oleks ohutud ja nauditavad kõigile.
-
Õnnelikud loomad
Oleme kasvanud loomade keskel üles, imetlenud neid vabas looduses. Seisame igati selle eest, et loomi koheldaks hästi. Oma toodetes ei kasuta me loomseid koostisosi ja oma tooteid me ei testi loomadel.
Auhinnad
Aesti tooted on teeninud mitmeid tunnustusi, kinnitades meie pühendumust kvaliteedile ja innovatsioonile ilumaailmas. Need auhinnad on meie klientide ja ekspertide positiivse tagasiside tunnustus ning innustavad meid jätkama tipptasemel nahahoolduse pakkumist.








Asutaja lugu
Tere,
Kui oled leidnud enda tee siinse infoni, oled ilmselt eriline inimene. Tõenäoliselt oled inimene, kes otsib midagi enamat — ja mul on siiralt hea meel, et meie teed ristusid.
Võib-olla on sinuni juba jõudnud sosinaid meie olemasolust… Või oled ehk nende õnnelike seas, kes on juba saanud kogeda AESTI looduslikku puudutust enda nahal ja juustel. Kui sa ei ole veel meie tooteid proovinud, kutsun sind avastusretkele. Sind võib oodata üllatus, mida ükski ilutoode ei ole sulle varem pakkunud — midagi ehtsat, toimivat ja hingega loodut.
Tõenäoliselt oled juba põnevil avastama, mida järgmised leheküljed endas peidavad, kuid enne seda soovin anda sulle lühikese ülevaate sellest, mis on AESTI ja miks me teeme seda, mida me teeme.
Minu nimi on Heiki Kanne ja olen Aesti Skincare’i asutaja. AESTI sünd on olnud pikk ja kirglik teekond — tee puhtusesse, põhjamaise looduse väesse ja päris ilu tähenduseni. Kui soovid meie loost rohkem teada, leiad siit alt lingi artiklile, mis ilmus 2024. aasta lõpus.
Soovin sulle head lugemist ja veelgi paremat toodete avastamist.
(Olen ausalt öeldes isegi veidi kade, et saad meie tooteid esimest korda kogeda — see on midagi erilist.)
https://thetycoonmedia.com/category/the-most-influential-leaders-in-beauty-industry-2024/